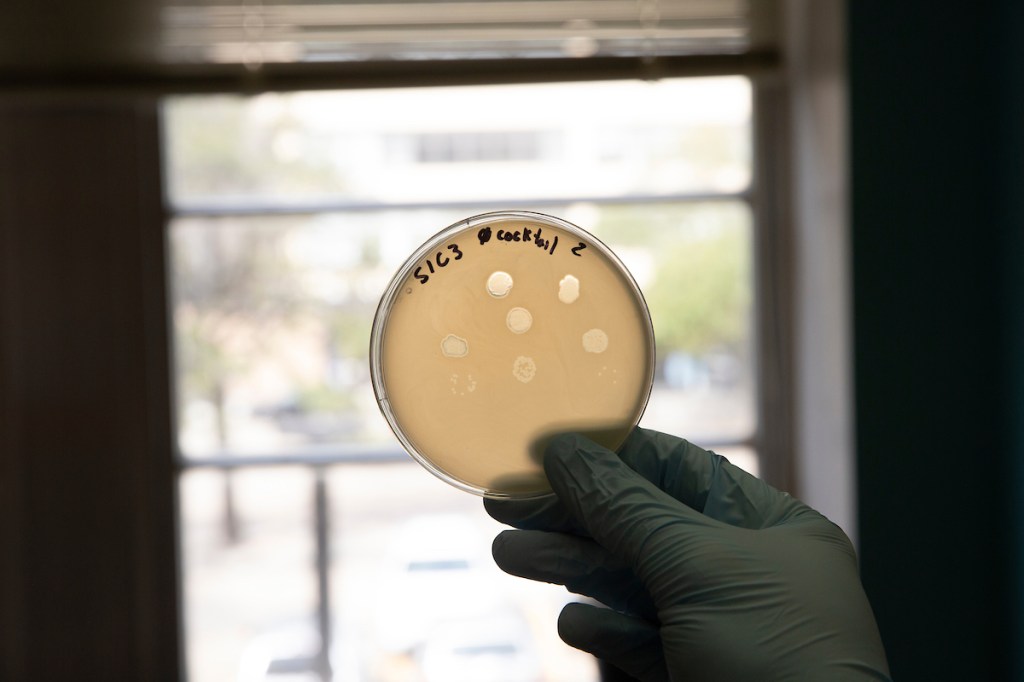
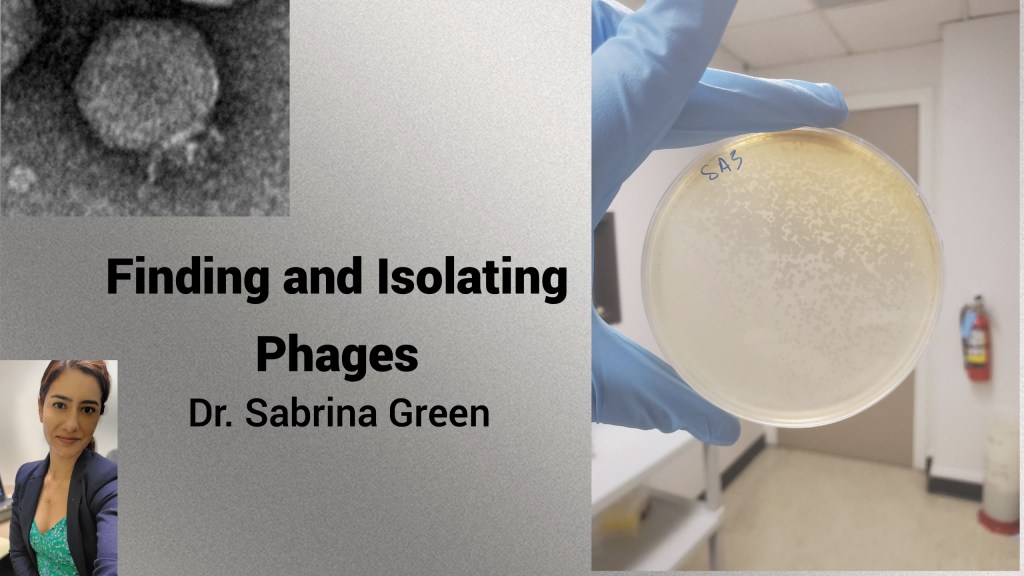

Phage scientist, patient advocate
Sabrina Green Ph.D.
I’m a research scientist with almost a decade of training in Microbiology. My passion is bringing awareness to the world of antimicrobial resistance. Also, helping patients dealing with AMR infections. Follow me @motherofphage on Twitter.
My passion is to bring awareness to the silent pandemic, antibiotic resistance.
What is the silent pandemic?
Antibiotic resistance is often called the “silent pandemic” a term used by the World Health Organization. According the CDC 2.8 million people are infected by antimicrobial resistant (AMR) organisms, yearly. We are going to reach a point where common infections may become life-threatening if this trend continues. The dire prediction is that 10 million people may die yearly due to AMR by the year 2050.
How can we prevent deaths due to antibiotic resistance?
New treatments are needed to combat antibiotic resistant infections. Bacteriophages or phages are viruses of bacteria first discovered in the 1900s and currently in use as a therapeutic in certain parts of the world. Phages use a different mechanism of killing bacteria than antibiotics and thus drug resistant bacteria can be susceptible to phage infection and killing. We can utilize phages, safely, to treat antibiotic resistant infections.
More about me – scientist
I cofounded and helped establish a group called TAILOR (Tailored Antibacterials and Innovative Laboratories for Phage Research) at Baylor College of Medicine in Houston, Texas, as a not-for-profit service center to source and prepare phages for patients with serious, drug-resistant infections. Since there are no approved phage drugs for infections by the U.S. Food and Drug Administration (FDA), the expanded access pathway is used for individual treatments via granting of approval through an investigational New Drug (IND) application. Thus far, TAILOR and its clinical partners in different institutions across the U.S. have worked together to treat a total of 12 patients using this pathway.
Now I am working at KU Leuven in Belgium as a researcher in Laboratory of Gene Technology. I am hoping to bring phage therapeutics to more people across the world in this position as well as solve scientific problems in the implementation of phage therapy.
What is unique about Belgium is its regulatory framework. Phages can be delivered in the form of Magistral preparations (compounding pharmacy preparations in the U.S.) to the patient upon prescription by the treating surgeon. The active pharmaceutical ingredient (API)—the phages, of magistral formulations are prepared according to a monograph. In this way physicians can prescribe the personalized phage preparations while hospital pharmacists prepare and dispense these prescriptions with the API or APIs (as different phage APIs can be combined at the pharmacy).

Science Communication
Part of my work is to run social media for our TAILOR group. I teach basic techniques in phage biology. Check out some of my videos below and follow our TAILOR labs YouTube channel. I take requests for new videos on techniques you are interested in seeing.

Things I’m interested in
- Public speaking
- Writing
- Patient advocacy
- Science advocacy